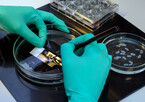

Mit der Zunahme von Schwangerschaftsdiabetes und metabolischen Störungen in der Schwangerschaft wird auch häufiger Metformin verschrieben. Obwohl bekannt ist, dass das orale Antidiabetikum die Plazentaschranke überwinden kann, sind die Auswirkungen auf die Gehirnentwicklung des Kindes weitgehend unbekannt. Ein interdisziplinäres Forscherteam des Deutschen Instituts für Ernährungsforschung Potsdam-Rehbrücke (DIfE) konnte nun im Mausmodell zeigen, dass Metformin zwar positive Folgen für die schwangeren Tiere, nicht jedoch für die Nachkommen hat. Veröffentlicht wurden die Ergebnisse im Fachjournal Molecular Metabolism.
Weltweit betrifft Schwangerschaftsdiabetes (Gestationsdiabetes) laut einer Pressemitteilung des DIfE etwa eine von sechs Schwangeren. In Deutschland waren 2021 laut Aussage des Robert Koch-Instituts bereits 63.000 Frauen erkrankt, Tendenz steigend. Diese Zahlen seien besorgniserregend, da zu hohe Blutzuckerspiegel während der Schwangerschaft mit negativen Folgen für Mutter und Kind einhergehen. So steige für die betroffenen Frauen das Risiko für einen späteren Typ-2-Diabetes und ihre Kinder haben ein höheres Risiko für Stoffwechselstörungen und Übergewicht.
Langfristige Metforminwirkung auf Nachkommen ist unklar
Wenn Lebensstiländerungen bei der Behandlung des Schwangerschaftsdiabetes keinen Erfolg zeigen, gewinnt seit einigen Jahren das plazentagängige orale Antidiabetikum Metformin als Alternative zur Insulingabe zunehmend an Bedeutung. Über die langfristigen Wirkungen von Metformin auf die Gesundheit der Nachkommen gebe es bislang jedoch nur wenige Studien. Bekannt ist, dass Metformin auf den AMPK-Signalweg wirkt, welcher während der Gehirnentwicklung die Vernetzung der Nervenzellen steuert.
Mit zwei zentralen Fragen setzte sich daher das interdisziplinäre DIfE-Forscherteam um Nachwuchsgruppenleiterin Dr. Rachel Lippert auseinander: Ist eine Behandlung mit Metformin nur für die Mutter oder auch für das Kind hilfreich? Und führt die Behandlung mit Metformin zu langfristigen negativen physiologischen Veränderungen bei den Nachkommen, insbesondere im Zusammenhang mit der Entwicklung der neuronalen Schaltkreise im Hypothalamus, einer kritischen Region für die Regulation des Energiehaushaltes?
Mausmodelle sollen Licht ins Dunkel bringen
Um Antworten auf diese Leitfragen zu finden, nutzten die Forschenden zwei Mausmodelle, welche die Hauptursachen für Schwangerschaftsdiabetes darstellen: starkes Übergewicht der Mutter vor der Schwangerschaft sowie eine übermäßige Gewichtszunahme während der Schwangerschaft.
Diese Stoffwechselzustände wurden durch unterschiedliche Fütterungsmuster erreicht, bei denen die Mäuse eine Hochfett- bzw. eine Kontrolldiät erhielten. Die antidiabetische Behandlung der weiblichen Mäuse und deren Nachkommen erfolgte während der Stillzeit, da diese hinsichtlich der Gehirnentwicklung dem dritten Trimester der menschlichen Schwangerschaft entspricht.
Die Therapie umfasste Insulin, Metformin oder ein Placebo, wobei die Dosierung an den menschlichen Standardtherapien orientiert war. Das Forscherteam sammelte Daten zum Körpergewicht der Mäuse, analysierte verschiedene Stoffwechselparameter und Hormone, und untersuchte molekulare Signalwege im Hypothalamus.
Mütterlicher Stoffwechselstatus ist entscheidend
„Infolge der antidiabetischen Behandlung in der frühen postnatalen Phase konnten wir Veränderungen im Gewichtszuwachs und im Hormonstatus der Nachkommen identifizieren, die entscheidend vom metabolischen Zustand der Mutter abhängig waren“, erklärt Lippert. Darüber hinaus zeigten sich geschlechtsspezifische Veränderungen in der hypothalamischen AMPK-Signalgebung als Reaktion auf die Metformin-Exposition. Zusammen mit der Metformin-induzierten Verschiebung der untersuchten Hormonspiegel deuten die Ergebnisse darauf hin, dass vor Beginn einer Therapie des Schwangerschaftsdiabetes der mütterliche Stoffwechselstatus berücksichtigt werden muss.
Prävention in den Fokus rücken
Laut Rachel Lippert könne die Therapie eines Schwangerschaftsdiabetes zukünftig darin liegen, eine für alle zugängliche und nicht plazentagängige Medikation zu entwickeln. „Angesichts der steigenden Prävalenz sind die Aufklärung über Schwangerschaftsdiabetes und präventive Maßnahmen von entscheidender Bedeutung. Wenn wir einen Weg finden, den Lebensstil und die Ernährung proaktiver zu gestalten, können wir das Potenzial zur Behandlung von Schwangerschaftsdiabetes besser ausschöpfen“, sagt Lippert.
Hintergrundinformationen: Metformin ist ein oral einzunehmendes Antidiabetikum, das den Blutzuckerspiegel senkt, indem es die Glukoseproduktion in der Leber hemmt und die Insulinsensitivität der Zellen erhöht. Es wird häufig als Erstlinientherapie für Menschen mit Typ-2-Diabetes verschrieben. Metformin wird entweder allein oder in Kombination mit anderen oralen Antidiabetika oder Insulinpräparaten eingesetzt. Die Europäische Arzneimittelkommission hat Metformin im März 2022 für die Behandlung in der Schwangerschaft zugelassen.
Diese Studie wurde im Rahmen der Deutschen Exzellenzstrategie des Bundes und der Länder durch die Deutsche Forschungsgemeinschaft (DFG) –EXC-2049– 390688087 (NeuroCure, RNL) und durch das Deutsche Zentrum für Diabetesforschung (DZD) –82DZD03D2Y und 82DZD03D03, RNL– unterstützt.
Quelle: Deutsches Institut für Ernährungsforschung Potsdam-Rehbrücke | Redaktion